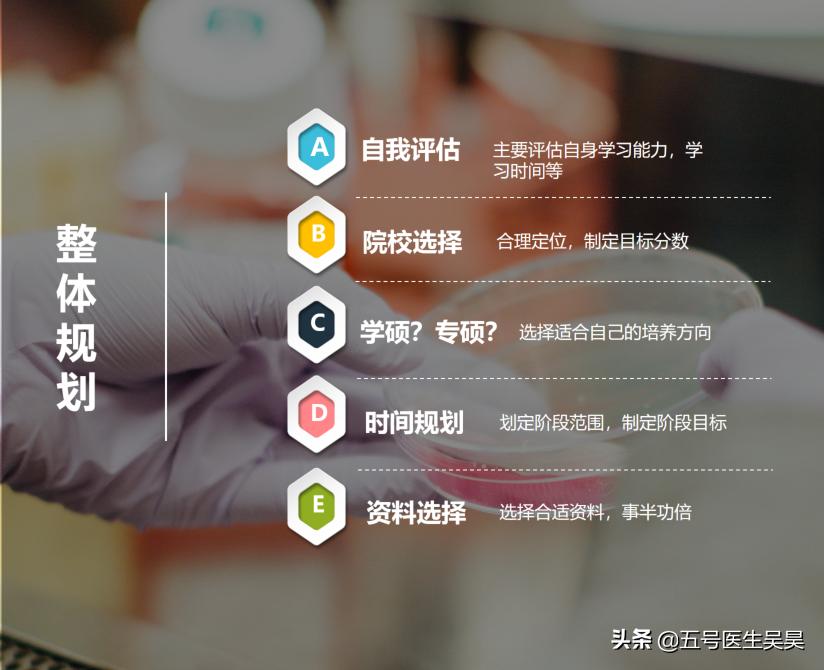
医学考研人文医学复习,医学考研怎么备考2023

前言
随着我国住院医师规范化培训的开展,考取临床医学专业型硕士被认为是医学本科毕业生"性价比"最高的选择,由此而来的就是逐年壮大的医学考研队伍。据统计,2019年全国硕士研究生报名人数290万人,较上一年增加了52万人,增幅达到21.8%,是近十年来增幅最大的一年,这其中又属医学类涨势最为凶猛。
伴随着报考人数的提升,分数线也显得不那么"矜持"了,国家线历年"稳中有升"也引起了一部分考生的焦虑。这种焦虑我有深切的体会,面对未知的挑战,尚未步入社会的学生们有时会显得举手无措。

考研人数逐年增长
为了缓解后辈们的焦虑,在当年参加完全考试并取得了较好的成绩后,我编写了万字长文与师弟师妹们分享,在那之后也被邀请作为兼职讲师负责某知名辅导机构的理论辅导和报考规划。今天,我就将这些年在医学考研辅导中总结的经验介绍给大家,希望能给马上要考试的同学们打打气,也为来年才参考的准考生们的备考工作给出一些建议。
考研需要整体规划
01 院校和专业的选择
先说两句:因为现场确认工作已经结束,所以这部分内容仅供参考,以免影响备考心情。虽然对已经现场确认的应届考生来说有些"鸡肋",但是关于院校和专业的选择是医学生考研过程中的重中之重,因此我仍需要把这部分拿出来稍微讲解一下。如果未来涉及调剂或明年才考试的准考生们可以放心阅读。
医学专业是目前为数不多的尚存在地域择业优势的主流学科,简单说来就是存在着"地方保护"或"本校保护":用人单位在同等条件或差距不大的情况下,更愿意录用本地培养的医学人才,造成这种局面的原因与各地医学院校附属医院的人才梯队建设和用人单位对本地医学培养模式的惯性思维和普遍信赖有关。试想一下,作为导师的科主任,哪个不希望把自己的得意门生留在身边呢。
与此同时,专业的选择要把自己的兴趣放在第一位,再去考虑专业未来的走向和在目标地区发展的前景。与大多数人的观点不同的是,我认为大多数情况下要把对院校的选择放在专业选择的前面去考虑,主要就是因为这种就业的"地方保护":留在哪里有时候比干什么更重要。

图为我国麻醉医师的地域分布
因此考生在了解自身能力和预估分数段后,一方面要考虑未来自己想要发展的地域,而另一方面要考虑心仪的专业在目标医院的实力情况,因为这个选择往往直接关乎着考生未来的职业走向。在地域和专业发生冲突时,倾向于优先考虑前者。
其实院校和专业的选择还有很多的细节需要关注,但最重要的就是提前将"就业问题"考虑进去,才不会出现专业选好了,院校也搞定了, 最后毕业的时候还要去别的城市卑躬屈膝地跪求别人的收留。

02 复习时间安排
在选定了目标专业和院校之后,就要奔着这个目标去努力了,科学合理的复习时间安排是确保考研顺利的最基础也是最重要的一环。
近些年每年的考研时间都会有微调,但一般都会在当年的年末进行,因此我建议考研复习的起始时间应该选定在头一年的年末或当年的年初。底子差的早点复习,底子好的晚点看书,但无论如何,我都建议尽量留出10个月以上的时间去复习考研,避免因报考纠结、生活琐事、毕业实习等因素对。
复习时间的安排从宏观上来说,在长达10个月甚至一年以上的复习中,要根据自身复习的进度规划出至少以下三个阶段:即基础阶段、强化阶段和冲刺阶段。不同的阶段有不同的效能,科学的时间规划会让整个复习拥有良好的节奏和优秀的效率。我建议在当年的7~8月前完成基础阶段的复习,十一长假前结束第二轮复习,也就是强化阶段,并在考试前1个月进入冲刺状态。
三个阶段有三个不同的复习状态,也有着不同的复习目标,接下来我们就看看,医学考研的三门科目在这三个阶段里都需要做些什么。

03 三个阶段都应该做什么
临床专业型硕士考试的内容是英语(100分)、政治(100分)和西医综合(300分),如果不是追求超一线的医学院校,考个340~360分是比较稳妥的。那么这就要求我们在复习过程中不能偏科,由于单科分数线的存在,一旦偏科就可能抱憾来年再战了。我的两位学生,在去年的考研中都是总分过线,但英语和政治分别差了1分而与复试失之交臂。
所以平衡而有侧重的安排三个科目的复习就显得格外重要,以下我讲的复习要点都是针对将分数预定为340~360分之间的同学们,学霸们请离场。
基础阶段:
一般这个阶段持续的时间最长,是应该夯实理论基础的阶段。在基础阶段我们暂时无需考虑政治的复习,要一门心思的把英语和西综的底子打好。
对于英语来说,这个阶段主要的任务就是背单词和看阅读,二者相辅相成,互相促进。
而西综的复习主要依赖的是大量地阅读教材和讲义,同时辅以授课的视频或音频,此时对于知识点的把握在广而不在精。
基础阶段是备考生们较为难熬的过程, 俗话说"万事开头难",由于考研复习的重点与平日里上课学习的不尽相同,哪怕是学霸们也要踏踏实实的"重头再来"(大学霸们都保研了…)。在这个阶段,复习完一门课就把上一课忘得一干二净、背了一天的单词隔日转头就忘的情况时有发生,因为这种挫败感而产生的焦虑、抑郁都会严重影响复习的进度,甚至有些人就此一蹶不振而倒在了这里。
其实大家大可不必恐慌,在基础阶段遇到这些情况再正常不过了,只要认真地把书看下去,在第二轮到来的时候一定会有所收获。切记,坚持最重要。

英语的三个阶段复习重点
强化阶段:
选择在十一前结束基础复习是为了让大家能够将第一阶段积攒的负面情绪通过十一假期调整一下,因为强化阶段的到来预示着备考生们的基础已经打好,需要进一步将其转化为脑中能够被调用的知识体系,而非单纯的死记硬背了。
在此阶段,政治的一些理论知识就应该接触接触了,想考80分以上的人在十一后就应该开始做选择题,但切记此时不必着急复习主观题,把精力留在后面即可。
英语和西综在正式进入强化阶段前可以挑一套近十年的真题过把瘾(记得把近五年的留好),在做真题的过程中体会考研的残酷和自身的不足一件很有意义的事情。在做完真题后,大家要像没事人似的继续开始复习的轮回,本阶段着构建知识体系的目的,将基础阶段复习的碎片化知识连线穿串,并适当做一下真题找找手感(同样是保留近五年真题)。等进入考试月,我们就该开始冲刺阶段了。

西综的三个阶段复习重点
冲刺阶段:
冲刺阶段是一个疯狂的时间段,此时我们复习的任务和目的非常明确,就是在短时间内进一步提高获取分数的手段:政治就是狂背大题,英语就是狂写作文(别忘了每天1~2篇真题阅读保持手感),西综就是疯狂的做真题并加以总结。
总之,这个阶段是将之前的所学所得进行强力输出,如果前阶段准备充分的同学,在这个阶段会逐渐建立起你的自信来,让你拥有一个更好的状态去参加考试。此前复习不好的同学也不用气馁,尤其是政治大题和英语作文,此时是提分的关键。有的放矢地挑重点复习,依然是可以"抢救"一下总体分数的。
以上就是关于医学考研复习的整体规划,下面我再给大家说几个小Tips,希望能对考生能有所启发和帮助。

政治的三个阶段复习重点
04 其他心得体会
Tips1:关于真题
在考研复习中,真题的价值是英语>西综>>>>>>政治的。
对于英语来说,反复地做真题阅读就是一个背单词,熟悉长难句的过程,同时真题中包含的解题信息和做题技巧也都是需要大量练习才能运用好的。英语对于真题的应用讲求一个熟练,如果想取得好成绩,至少做三遍以上才能有把握。
西综真题的应用与英语稍微有些不同。英语真题只要做熟练了自然就有收获,但西综的真题必须要仔细研究和总结才能为我们所用。在这里给大家传授一个我的"祖传"秘籍,就是把近5~8年的西综真题里出现的所有知识点(无论正确选项还是干扰项)都用不同颜色的笔在讲义上一一标出,这样所有的考试重点一目了然,比任何一个讲师给你划重点来的都印象深刻。
而政治的真题,几乎没有任何研究的意义,大家不要浪费时间在这上面。

历年考点跃然于纸上
Tips2:关于复习资料的选择
经过我花了近5000元购买复习资料和视频的经验告诉我,无论哪个材料或机构,只要是通过正规渠道了解到的,在群众中有一定口碑的,抓住一个看准没错。考研复习的大忌之一就是频繁的更换复习材料,这么做会严重干扰复习的进度和节奏,反而影响成绩。
对于额外的复习资料来说,政治>>>>>>西综>>>英语。选择一本好的政治资料简直是事半功倍,至于选择哪个,去各大论坛看看口碑是不会让你选错的。而其他的材料或复习辅导形式则需要根据考生实际情况来看,在这里我想说的是视频教学对于自制力一般或复习规划能力差的人来说是非常好的辅助,建议购买。

教科书才是最好的复习材料
Tips3:顺口溜和画图有奇效
对于一些晦涩难懂的知识点,通过画图和顺口溜的记忆会有"柳暗花明"的感觉。比如对于抗结核药物的记忆,单纯的罗列知识点对于考生们来说背诵难度极大,但是把它变成"以后一周练听力,利肝安胃肠"的口诀就显得轻松了许多。这个口诀里不仅把5中常规抗结核药物列举出来,还分别提示了其相对应的副作用,记忆效率极高。

口诀总结的小本
画图则常被用来帮助记忆复杂的生理或病理机制,比如生化中经典的糖代谢途径,通过画图可以将糖代谢的每一步反应和关键酶重点突出的表现在纸上,增强视觉记忆的同时,也强化了对这个路径生化知识的理解。
因此,考研复习并不是死记硬背,掌握更多的方式方法相互配合才会有更佳的效率。

动手画图记忆效果更好
总结
考研对于医学生来说真的是越来越难了, 猛然回首才发现距离曾经的辅导一线已经过去那么久了。今日偶然看到头条关于考研的征文心生怀念,谨以此文献给正在奋斗或即将奋斗在考研战场的学弟学妹们,希望我的文章能够给你们一些启发或帮助。未来时机成熟我也希望可以成系统的将这些心得归纳,升级为专栏文章供大家参考。
最后希望大家能够金榜题名,早日加入我们的行列,为祖国健康事业做贡献~
